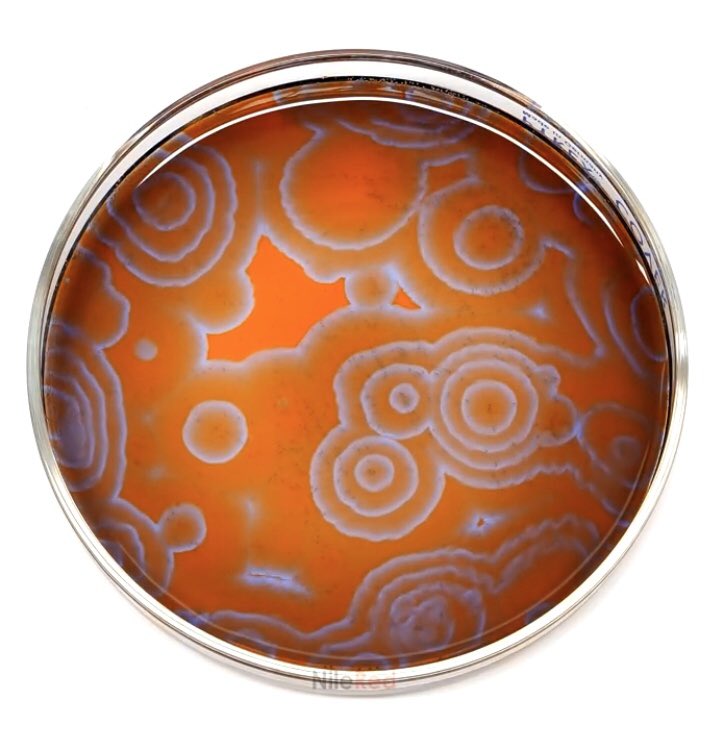

https://www.youtube.com/user/TheRedNile
https://www.youtube.com/user/TheR... href=" https://www.youtube.com/user/cienciabit ">https://www.youtube.com/user/cien...
Check this out  https://abs.twimg.com/emoji/v2/... draggable="false" alt="👇🏻" title="Down pointing backhand index (light skin tone)" aria-label="Emoji: Down pointing backhand index (light skin tone)"> https://twitter.com/niallanalysis/status/1250121241857572867">https://twitter.com/niallanal...
https://abs.twimg.com/emoji/v2/... draggable="false" alt="👇🏻" title="Down pointing backhand index (light skin tone)" aria-label="Emoji: Down pointing backhand index (light skin tone)"> https://twitter.com/niallanalysis/status/1250121241857572867">https://twitter.com/niallanal...

 Read on Twitter
Read on Twitter